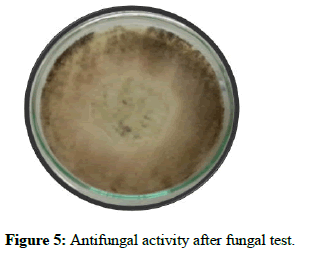

Case Report, J Fashion Technol Textile Vol: 11 Issue: 5
Development of Biodegerable EcoFriendly Herbal Coated Sanitary Napkin
Sumithra Murugesan*
Department of Textiles and Apparel Design, Bharathiar University, Tamil Nadu, India
*Corresponding Author: Sumithra Murugesan
Department of Textiles and
Apparel Design, Bharathiar University, Tamil Nadu, India
E-mail: sumitad@buc.edu.in
Received date: 06 June, 2022, Manuscript No. JFTTE-23-59798;
Editor assigned date: 09 June, 2022, PreQC No. JFTTE-23-59798 (PQ);
Reviewed date: 23 June, 2022, QC No. JFTTE-23-59798;
Revised date: 19 May, 2023, Manuscript No. JFTTE-23-59798 (R);
Published date: 16 June, 2023, DOI: 10.4172/2329-9568.1000303
Citation: Murugesan S (2023) Development of Biodegerable Eco-Friendly Herbal Coated Sanitary Napkin. J Fashion Technol Textile 11:3.
Abstract
Sanitary napkins are available now are non-biodegradable and also cause severe infections there by affecting women’s health through the chemical dioxins are toxic and carcinogenic. Considering this drawback, sanitary napkins are made of natural fibres to overcome this challenge. In the present study, naturally available bamboo fiber and cotton fibre which are easily available, biodegradable and cost effective were used. Another advantage of using the natural materials was their characteristics like porosity and retention of fluid for a longer time. Selected herbs were coated on sanitary napkins and the performance of sanitary napkin was assessed by antibacterial activity, antifungal activity and anti-odor test. This study proved that biodegradable material and herbal coated disposable sanitary napkin confirm that the sanitary napkins treated with herbs has sufficient properties and are safer to use than the available commercial napkins are hygienic and 100% ecofriendly.
Keywords: Antibacterial activity, Bamboo fibre, Cotton fibre, Eco friendly and sanitary napkins
Introduction
Historically, women felt that menstruation was something to be ashamed of, a feeling that is still prevalent in society and popular culture today. Feminine pads are used for menstrual hygiene by women approximately 14-49 years old. The selection of sanitary protection is very much a personal decision based on user preferences and cultural acceptability. It is also influenced by the girl’s exposure, water supply and affordability options. Women’s sanitary napkins should provide comfort and safety and also improve every woman’s health and lifestyle. Women place these napkins next to the most delicate and absorbent tissue in our body [1].
Cotton fibres are particularly suitable for manufacturing textiles for sports, non-implantable medical products and health care/hygienic product. However the ability of cotton fibres to absorb large amount of moisture makes them more prone to microbial attack under certain conditions of humidity and temperature [2].
Bamboo fibre is a cellulose fibre extracted or fabricated from natural bamboo and possibly other additives and is made from (or in the case of material fabrication) the pulp of bamboo plants. It is usually not made from the fibres of the plant, but is a synthetic viscose made from bamboo cellulose [3].
The use of plants and plant products could be traced as far back as the beginning of human civilization. Medicinal plants are a source of great economic value all over the world. The objectives of the study are:
• To select natural fibre for the sanitary pad.
• To screen for sanitary napkin from selected herbs.
• To produce 100% eco-friendly sanitary pad.
• Designing of the eco-friendly and biodegradable sanitary napkin.
• Apply fragrance finish (lily) for the samples.
• To evaluate the antibacterial activity, antifungal activity and antiodor
test.
Materials and Methods
Selection of fiber
Cotton fibre and mercerized bamboo fibre is used for this study. Bamboo cotton fibre has good absorbency and more over bamboo has anti-bacterial character in nature [4].
Selected best four herbs
The selected four herbs are shown in Figure 1 are Azadirachta indica, Hibiscus sabdariffa, Saraca asoca and Ocimum tenuiflorum. The selected herbs based on the zone of incubation, evaluated under AATCC 147 test method [5].
Production of 100% eco-friendly sanitary napkin
The sanitary napkin design is based on the conventional three layered design with top transferable layer and absorbent core and a barrier sheet [6].
Top sheet: It is designed to transfer fluid quickly from the top sheet to secondary layers. Top sheet, a thin layered web of cotton non-woven-4 grams fibre was needled punched onto 100% cotton nonwoven fabric. Antimicrobial herbs such as Azadirachta indica, Hibiscus sabdariffa, Saraca asoca and Ocimum tenuiflorum was applied on to the top layer in equal proportions [7].
Raw material used for top sheet:
• Cotton is one the commonly advised raw material for sanitary
napkin because of its non-irritant, skin friendly and superior liquid
retention properties.
• It is soft and breathable which gives comfort and dryness.
• Cotton wicks away moisture and keeps skin dry and PH
compatibility makes it skin friendly.
Absorbent core: It is interposed between top sheet and barrier layer main function is to absorb and retain fluid. Moreover, to have comfort, absorbent core need to be thin, soft and pliable. For absorbent core insert natural fibers such as cotton-24 grams, bamboo-3 grams and 2 grams of herbal Azadirachta indica, Hibiscus sabdariffa, Saraca asoca and Ocimum tenuiflorum are mixed in equal proportions and sprinkled, 1 gram of garlic and onion is used in absorbent core to protect from pesticides [8].
Raw material used for absorbent core: The primary requirement of sanitary pad is absorbency of menstrual fluid.
• Therefore, selection of core material totally depends on the
absorbency and retention property of fibre.
• Bamboo fibre is a novel alternative raw material for absorbent core.
• Bamboo absorbs and wicks water 3-4 times better than cotton and
reduces odor as the fibre is filled with multiple micro-holes and
micro-gaps.
• Bamboo is soft to feel as the fibre is naturally round in shape it does
not require any chemical treatment to smoothen it.
• Significant property of bamboo is the anti-microbial agent.
Barrier sheet: It seals the fluid from staining or leakages. For a barrier layer, biodegradable low density polyethylene film was used, this makes the entire sanitary napkin eco-friendly. For fragrance finish lily coated over all the samples [9].
Raw material used for barrier sheet
• Polyethylene is widely used protective film in hygiene products.
• It is biodegradable in nature.
The 100% eco-friendly prepared sanitary napkin shown in Figures 2 and 3.
Evaluation of antibacterial activity (AATCC test method 147-2004)
AATCC test method 147-2004 (Parallel streak method): Using a 4 mm inoculating loop, one lapful of the diluted inoculums was transferred to the surface of agar plates as per test method. Test specimen were placed onto inoculated agar plate transversely across the inoculums streaks and incubated for 18-24 hr at 37°C, thereafter examined for interruption of growth along the streaks of inoculums beneath the specimen and for a clean zone of inhibition beyond its edge [10].
Evaluation of antifungal activity (AATCC 30-1993)
AATCC 30-1993: Antifungal activity, assessment on textile materials, mildew and rot resistance of textiles (humidity jar method). 500 ml sterile conical flasks containing of PD broth were prepared. The test samples were transferred aseptically into the conical flasks and kept at room temperature for three days. Then the growth of fungi in the conical flask was observed after three days [11].
Evaluation of anti-odor test (ASTM WK67186)
Odor control is one of the top performance criteria in disposable feminine care products. Currently, there is no standard for this testing. This standard can be used by product developers to test and understand material/product odors as well as the odor control effectiveness of these materials and final products. According to the type of fibers and other items used, based on that odor test can be done. Fragrance lily coated for all samples [12].
Results and Discussion
Evaluation of antibacterial activity AATCC test method 147-2004
From the Table 1 and Figure 4. The assessment of antibacterial activity against the bacteria namely Escherichia coli and Staphylococcus aureus as shown for 100% eco-friendly sanitary napkin. Absence of bacterial colonies under the specimen in the contact area is considered as an acceptable antibacterial activity. Thus the result is found to having very effective antibacterial activity against Staphylococcus aureus. The control specimen shows no zone of inhibition for both gram positive organism and gram negative organism (Figure 4) [13].
| Organisms | Zone of inhibition (mm) duplicates | |
|---|---|---|
| Escherichia coli | 3.2 | 3.1 |
| Staphylococcus aureus | 4.7 | 4.8 |
Table 1: Antibacterial activity.
Evaluation of antifungal activity-AATCC 30-1993
Results confirm that the sanitary napkins treated with herbs has sufficient antifungal properties and are safer to use than the available commercial napkins and untreated napkins. It is noted that no mildew and rot found, no fungal effect, passes the test as shown in Figure 5 [14].
Evaluation of anti-odor test ASTM WK67186
Fragrance lily coated for samples. Eight persons used sanitary napkin for 5 days 6 to 8 hours and they concluded that odor is very important for the sanitary napkin, because it changes the mind during menstrual cycle; it especially rejuvenates the mind during the period. Odor of the herbal balances and locks the smell of the blood. Fragrance lily coated for all samples. There is no bad odor found in samples [15].
Conclusion
Sanitary pads are used in prolonged contact with the skin pose major health hazards, due to the various chemicals used in manufacturing such as chlorine bleaching which releases dioxin as a by-product. Though eco-friendly sanitary pads are available in the market, customers have not fully accepted those products. Therefore this study aims to find the factor which prohibits customers from using eco-friendly sanitary pads.
Development of a sanitary pad from cotton fibre and bamboo fibre, which would possess superior performance qualities, affordable and biodegradable is highly recommended. Herbal coated disposable sanitary napkins to bio degerable napkins confirm that the sanitary napkins treated with herbs has sufficient properties and are safer to use than the available commercial napkins.
References
- Woeller KE, Hochwalt AE (2015) Safety assessment of sanitary pads with a polymeric foam absorbent core. Reg Toxicol Pharmacol 73: 419-424.
[Crossref] [Google Scholar] [PubMed]
- Ravindra S, Mohan YM, Reddy NN, Raju KM (2010) Fabrication of antibacterial cotton fibres loaded with silver nanoparticles via green approach. Coll Surf Physicochem Eng Asp 367: 31-40.
- Ripa FA, Nahar L, Fazal A, Khatun MH (2012) Antibacterial and phytochemical evaluation of three medicinal plants of Bangladesh. Int J Pharm Sci Res 3: 788-792.
- Sumithra M (2023) Evaluation of 100% eco-friendly herbal coated sanitary napkin. Intern Res J Innov Eng Technol 7: 86.
- Sareen S (2021) Sustainable menstrual alternatives: The journey so far. Intern J Home Sci 7: 216-219.
- Balda S, Sharma A, Capalash N, Sharma P (2021) Banana fibre: A natural and sustainable bioresource for eco-friendly applications. Clean Technol Env Pol 23: 1389-1401.
- Banappagoudar SB, Mayank DR, Kripa N, Kanna RK, Kurian NK (2021) Anti-bacterial sanitary napkin using biomaterial application. Nveo-nat Volat Ess Oils J 8: 12254-12263.
- Sumithra M (2023) Market survey on feminine hygiene products for sanitary napkin. Intern Res J Innov Eng Tech 7: 24.
- Rajput A, Ramachandran M, Gotmare VD, Raichurkar PP (2017) Recent bioactive materials for development of eco-friendly dippers: An overview. J Pharm Sci Res 9: 1844-1848.
- Sathishkumar G, Aarthi M, Senthilkumar R, Nithiya P, Selvakumar R, et al. (2019) Biodegradable cellulosic sanitary napkins from waste cotton and natural extract based anti-bacterial nanocolorants. J Indian Inst Sci 99: 519-528.
- Singh P, Srivastava A, Bhatnagar E (2023) Exploration of various issues associated with sustainable use of sanitary napkins. J Appl Sci Educ 3: 1-8.
- Shibly MMH, Hossain MA, Hossain MF, Nur MG, Hossain MB (2021) Development of biopolymer-based menstrual pad and quality analysis against commercial merchandise. Bull Nat Res Centr 45: 1-13.
- Joshi M, Purwar R, Ali SW, Rajendran S (2010) Antimicrobial textiles for health and hygiene applications based on eco-friendly natural products. Med Healthcare Tex 5: 84-92.
- Venkatraman PD, Sayed U, Parte S, Korgaonkar S (2021) Development of advanced textile finishes using nano-emulsions from herbal extracts for organic cotton fabrics. Coatings 11: 939.
- Gulati R, Sharma S, Sharma RK (2022) Antimicrobial textile: Recent developments and functional perspective. Poly Bul 79: 5747-5771.
[Crossref] [Google Scholar] [PubMed]
Spanish
Chinese
Russian
German
French
Japanese
Portuguese
Hindi